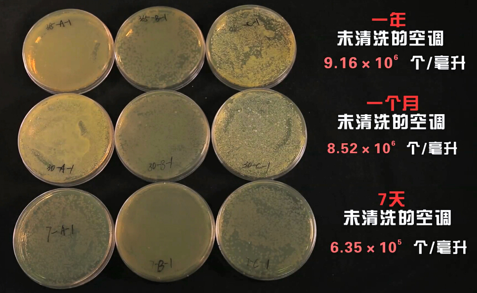

今夏的炎热可谓有些姗姗来迟,然而随着大暑一过,近日来全国各地气温纷纷升高,越来越多的地区进入了“烧烤模式”,市民们家中休息了许久的空调也纷纷准备上岗,但是在三伏天享受夏日清凉的同时,如果不加注意,空调也很容易成为家中的健康隐患。
三伏天使用空调警惕空调疾病
近期,医院门诊中有很多人尤其是小儿突发感冒,或者伴随咳嗽不停,或者伴随发烧不退等症状,究其原因多半是因为夏季空调导致。因为三伏天本身体内就容易积热,再加上空调的冷气外袭,于是这种“寒包火”的格局就很容易形成。
除了感冒发烧,呼吸道疾病患者也开始增多,不少市民反映,闲置了多时的空调开启后有一股怪味,在空调房内待得时间一长,会产生一些不适症状。据中国环境科学学会室内环境与健康分会的专家李景广解释,这种情况,很可能就是空调散热片中的细菌和霉菌在作怪。
空调过滤网背后的散热片是真正污染源
CCTV、湖南卫视等权威媒体曾经就空调散热片污染问题深入调查,调查结果相当惊人。绝大多数家庭的空调散热片存在污染的情况,而一台污染的空调只需一晚的时间就可以将一条白毛巾吹成黑色。
根据中国环境科学学会和复旦大学发布的室内空气污染研究报告,夏季室内空气污染较户外高出4-5倍,上海、北京和深圳受访家庭中,近9成的室内空调散热片细菌超标,最高的超标竟达1000倍,其细菌和霉菌含量远超马桶和抹布。专家表示,这空调散热片正是空调污染的罪魁祸首。空调散热片是冷热空气交汇聚集之地,提供的温度、湿度等条件则刚好容易成为霉菌、细菌滋生的温床。而散热片位于过滤网之后,结构特殊,不可拆卸,用抹布、刷子清洁不但无法清洁,反而容易造成损坏,因而最容易成为清洁盲区。


三伏天更应每月清洗一次空调散热片
那么到底该如何清洁空调散热片呢?其实购买空调消毒剂进行DIY是一个不错的选择,既免去了专业人员上门清洗的麻烦,价格上也更加经济实惠。作为一年里气温最热,湿度最大的时间段,三伏天加速了空调散热片中霉菌、细菌的增长,上海家化家安品牌联合实验机构进行了一场实验,取样调查后发现,30天未清洗的空调在菌落大小和数量上与一年未清洗的空调相差无几,这说明空调细菌量在一个月时接近饱和。因此专家建议,在三伏天使用空调,更应勤洗,在空调使用频繁的夏季,应该保证每月至少清洗一次空调散热片。

空调是夏季居家必不可少的电器,与我们呼吸与共,对于它的清洁消毒也就变得更为重要。此外,家用空调在清洗后,有利于提高制冷、热效率,延长家用空调机设备的寿命,提高节能效果,可谓一举两得。